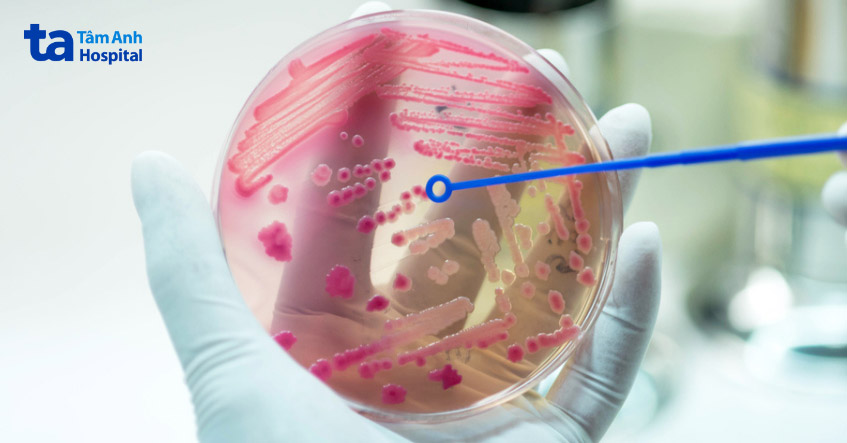
quan hệ tình dục khi bị viêm bàng quang sẽ đưa nhiều vi khuẩn hơn vào bàng quang

Khi bị viêm bàng quang, các sinh hoạt thường ngày có thể bị ảnh hưởng, trong đó có đời sống tình dục. Nhiều người lo lắng không biết bị viêm bàng quang có quan hệ được không? Cần kiêng trong bao lâu? Bài viết này được bác sĩ CKI Lý Minh Hoàng, Trung tâm Tiết niệu – Thận học – Nam học, Bệnh viện Đa khoa Tâm Anh TP.HCM giải đáp kỹ hơn.

Việc quan hệ tình dục được hay không còn tùy thuộc và nguyên nhân, triệu chứng và mức độ của tình trạng viêm bàng quang của người bệnh. Thông thường, bác sĩ khuyên người bệnh kiêng quan hệ khi điều trị viêm bàng quang, cho đến khi bệnh khỏi hẳn, vì quan hệ tình dục cũng là nguyên nhân gây viêm bàng quang khiến bệnh nặng hơn. Chính vì thế viêm bàng quang có quan hệ được hay không cần phải được thăm khám kĩ lưỡng.
Để biết được chính xác ở trường hợp cụ thể khi bị viêm bàng quang có quan hệ được không cần xác định nhiều yếu tố khác nhau trước khi đưa ra kết luận, như:
Thông thường, nữ giới dễ bị viêm bàng quang và tái phát bệnh sau điều trị hơn nam giới, do cấu tạo niệu đạo ngắn. Khi nữ giới quan hệ trong lúc bị viêm bàng quang có thể kéo giãn niệu đạo, tạo điều kiện cho vi khuẩn từ âm đạo xâm nhập và đi sâu vào bàng quang, làm bệnh trở nặng hoặc tạo điều kiện cho viêm bàng quang tái phát. Bên cạnh đó, khi quan hệ, cơ thể nữ giới sẽ tiết ra endorphin, gây ức chế tại chỗ, từ đó tạo điều kiện cho vi khuẩn gây viêm nhiễm phát triển mạnh.
Người có triệu chứng viêm bàng quang nhẹ vẫn có thể quan hệ tình dục được, nhưng các bác sĩ không khuyến khích điều này. Trước khi quan hệ, cần vệ sinh bộ phận sinh dục đúng cách bằng các dung dịch vệ sinh lành tính, không gây kích ứng, đi tiểu ngay sau khi quan hệ để loại bỏ vi khuẩn ra khỏi bàng quang.
Bị viêm bàng quang quan hệ được không? Nhìn chung, dù không có bất kỳ chống chỉ định nào cho việc quan hệ tình dục khi đang điều trị viêm bàng quang; tuy nhiên, để tránh bệnh diễn biến nghiêm trọng hơn, tạo điều kiện thuận lợi cho điều trị, bác sĩ khuyến cáo không quan hệ tình dục trong khoảng thời gian này.

Với câu hỏi viêm bàng quang có nên quan hệ không? Bác sĩ khuyên không nên quan hệ khi đang bị viêm bàng quang, vì điều này có thể làm tình trạng viêm trở nên nặng hơn, gây khó khăn trong quá trình điều trị.
Việc kiêng quan hệ trong khi bị viêm bàng quang sẽ giúp bảo vệ bàng quang khỏi tấn công của vi khuẩn bên ngoài niệu đạo, tránh tình trạng giãn niệu đạo, gây tổn thương khiến viêm sưng thành bàng quang ngày càng nghiêm trọng. Trong một số trường hợp, viêm bàng quang có thể do quan hệ tình dục gây ra, nhiễm trùng có thể lây lan từ bàng quang đến thận và gây nguy hiểm đến sức khỏe. (1)
Các bác sĩ thường khuyên nên kiêng quan hệ tình dục cho đến khi viêm bàng quang được điều trị khỏi hoàn toàn. Việc quan hệ tình dục có thể gây kích ứng đường tiết niệu và có thể đẩy vi khuẩn vào niệu đạo, khiến tình trạng nhiễm trùng trở nên trầm trọng hơn.
Khi bị viêm bàng quang, quan hệ tình dục có thể gây đau và khiến niệu đạo nhạy cảm. Ở phụ nữ, áp lực lên thành trong của âm đạo cũng có thể gây áp lực lên bàng quang, làm tăng thêm cơn đau do nhiễm trùng tiểu. (2)
Quan hệ tình dục cũng có thể đẩy vi khuẩn từ những nơi khác xung quanh vùng sinh dục vào niệu đạo, đến bàng quang. Đặc biệt ở nữ giới, quan hệ tình dục thường xuyên là một yếu tố nguy cơ phát triển viêm bàng quang và các bệnh về nhiễm trùng tiểu (UTI) khác. Quan hệ khi nhiễm trùng vẫn còn làm tăng nguy cơ đưa nhiều vi khuẩn vào đường tiết niệu hơn. Điều này có thể làm cho tình trạng nhiễm trùng nặng hơn và làm chậm quá trình lành vết thương.
Bất kỳ sự tiếp xúc nào với bộ phận sinh dục đều có thể đưa vi khuẩn vào niệu đạo. Vì vậy, để giảm thiểu rủi ro, nên tránh mọi hình thức quan hệ tình dục cho đến khi các triệu chứng biến mất hoàn toàn và bệnh được điều trị khỏi.
Xem thêm: Viêm bàng quang bao lâu thì hết bệnh?
Ngoài bâng khuâng về việc khi bị viêm bàng quang có quan hệ được không? Nhiều người cũng e ngại, không biết nếu vô tình quan hệ khi viêm bàng quang có sao không? Việc quan hệ khi bị viêm bàng quang có thể khiến người gặp phải nhiều vấn đề về sức khỏe như:
Khi bị viêm bàng quang, quan hệ sẽ khiến người bệnh cảm thấy đau rát, khó chịu, cơn đau do viêm bàng quang sẽ trở nên nặng hơn sau mỗi lần quan hệ. Bên cạnh đó, quan hệ khi bị viêm bàng quang làm xuất hiện thêm các triệu chứng khác như đau lưng, ớn lạnh,… làm bệnh tiến triển xấu đi mỗi ngày.
Bất kỳ hoạt động tình dục nào khi bị viêm bàng quang cũng khiến người bệnh đối mặt với nguy cơ nhiễm trùng nặng hơn. Các hoạt động tình dục có thể đưa vi khuẩn bên ngoài tấn công sâu vào đường tiết niệu, không những tân công bàng quang, vi khuẩn có thể lan sang các bộ phận lân cận trong đường tiết niệu như niệu đạo, tuyến tiền liệt, thận,…
Nếu không sử dụng các biện pháp an toàn như dùng bao cao su, có thể khiến vi khuẩn gây viêm bàng quang lây cho bạn tình. Thông thường, vi khuẩn gây viêm bàng quang có thể xuất hiện ở âm đạo, niệu đạo, chính vì vậy, chúng có thể bám vào bộ phận sinh dục và xâm nhập vào đường niệu đạo khi quan hệ.
Quan hệ tình dục có thể làm các triệu chứng viêm bàng quang nặng hơn. Việc đưa nhiều vi khuẩn vào bàng quang khi quan hệ khiến bàng quang sưng, viêm nặng hơn, từ đó làm chậm quá trình điều trị, chữa lành tổn thương do viêm nhiễm.
Bị viêm bàng quang quan hệ được không? Bệnh ảnh hưởng rất nhiều đến đời sống tình dục của người bệnh. Để có thể vừa thỏa mãn nhu cầu sinh lý, vừa đảm bảo sức khỏe, bác sĩ khuyên người bị viêm bàng quang có thể áp dụng những cách làm giảm viêm khi quan hệ. Điều này vừa giúp đời sống tình dục viên mãn, vừa không khiến bệnh tiến triển xấu nhanh hơn.

Để biết chính xác với trường hợp của từng người bệnh, khi bị viêm bàng quang có quan hệ được không nên tham khảo ý kiến bác sĩ. Dựa trên triệu chứng, mức độ nhiễm trùng, nguyên nhân gây bệnh, bác sĩ sẽ giúp đưa ra lời khuyên về việc khi bị viêm bàng quang có nên quan hệ không? Điều chỉnh tần suất như thế nào? Cần lưu ý điều gì?
Việc chữa trị viêm bàng quang kịp thời, loại bỏ hoàn toàn nguyên nhân gây bệnh có thể giúp phục hồi sức khỏe đường tiết niệu, giúp bạn thoải mái và có đời sống tình dục viên mãn hơn.
Trung tâm Tiết niệu – Thận học – Nam khoa, BVĐK Tâm Anh TP.HCM là cơ sở y tế được nhiều người bệnh viêm bàng quang tin tưởng lựa chọn cho việc chẩn đoán và điều trị các bệnh liên quan đến nhiễm trùng tiểu, thận, tiết niệu, nam khoa, trong đó có viêm bàng quang. Các bác sĩ ở trung tâm sẽ giúp chẩn đoán và tìm ra nguyên nhân gây bệnh, điều trị khắc phục triệu chứng và loại bỏ nguyên nhân gây viêm bàng quang.
HỆ THỐNG BỆNH VIỆN ĐA KHOA TÂM ANH
Hy vọng với những thông tin mà chúng tôi vừa chia sẻ đã giúp bạn biết được việc bị viêm bàng quang có quan hệ được không? Cần lưu ý những gì khi quan hệ để bệnh không diễn biến xấu. Quan hệ tình dục là hoạt động sinh lý bình thường ở người, giúp đời sống vật chất lẫn tinh thần trở nên đủ đầy, viên mãn, đừng để viêm bàng quang ảnh hưởng đến sinh hoạt hàng ngày, làm giảm chất lượng cuộc sống của chính bạn.